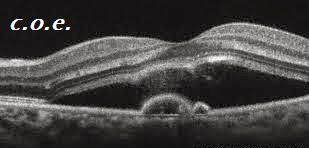

Las
células madre embrionarias para la DMAE: Una promesa cumplida?
Las
células madre embrionarias a mejorar la visión,
La
promesa de las células madre embrionarias (CME) parece no tener límites. A
partir de las lesiones de la médula espinal a la diabetes, al tratamiento de
enfermedades de la retina previamente intratables; las CME parece ser la
respuesta largamente esperada a enfermedades degenerativas crónicas. La magia
de las CES radica en su pluripotencia-la capacidad de diferenciarse en todos
los tipos de células en el cuerpo.
Específico
para el ojo, las CME pueden ser útiles en la distrofia macular de Stargardt y
en la degeneración macular no exudativa relacionada con la edad (DMAE),
enfermedades caracterizadas por la disfunción del epitelio pigmentario de la
retina (EPR). El EPR es compatible con la viabilidad de los fotorreceptores
adyacentes, y es posible que mediante el trasplante de células del EPR derivadas
de las CME, la degeneración de los fotorreceptores podría detenerse.
La
CME, sin embargo, no dejan de tener sus preocupaciones. Existe una gran
controversia sobre la ética de la utilización de células que sólo se pueden
obtener a partir de embriones. También hay riesgos asociados con las CME ,
incluyendo la formación de teratomas y la posibilidad de las CME de
diferenciarse en tipos de células no deseadas. También se puede producir el
rechazo inmunológico, pero como el ojo siendo es en gran medida
inmunoprivilegiado, es un lugar ideal para explorar el uso de las CME, y las
posibilidades de rechazo se reduce al mínimo.
Schwartz
y sus colegas investigaron el uso de las CME en el tratamiento de la DMAE y la
distrofia macular de Stargardt. Dieciocho ojos fueron incluidos en el estudio:
nueve con DMAE y nueve con distrofia macular de Stargardt. Para ser incluidos
en el estudio, la agudeza visual tenía que ser de 20/200 o peor, y sólo un ojo
por paciente podría estar incluido.
Se
llevó a cabo el trasplante subretiniano de las CME, y los pacientes recibieron
una de tres cantidades de CME: 50.000 células, 100.000 células, o 150.000
células. Los pacientes recibieron tratamiento inmunosupresor sistémico para
minimizar el rechazo del trasplante y fueron seguidos durante una media de 22
meses.
Los
principales criterios de valoración fueron la seguridad y la tolerabilidad del
tejido trasplantado. El criterio de valoración secundario fue la eficacia, e
incluía medidas como la agudeza visual, pruebas de campo visual, electroretinograma,
encuestas de calidad de vida, y el análisis de la tomografía de coherencia
óptica.
Trece
de los 18 pacientes aumentaron las áreas de pigmentación subretiniana , con mayor
frecuencia en la frontera de la zona atrófica. Aunque el aumento postoperatorio
parece prometedor, no hubo correlación entre el aumento de pigmentación de la
retina y la mejora visual. La agudeza visual mejoró significativamente en 10
pacientes, se mantuvo casi igual en siete ojos, y empeoró en un ojo en 10
letras. El ojo no tratado de cada paciente no presentaba mejoría en la agudeza,
proporcionando evidencia de que el trasplante fue responsable de la mejora de
la agudeza. El campo visual, la perimetría
estática, el electroretinograma, y la velocidad de lectura se evaluaron, pero
no hubo diferencias preoperatorias y postoperatorias.
Es
de interés que las medidas de calidad de vida como la percepción de la visión
general y la visión de cerca mejoraron entre 16 y 25 puntos en el grupo de DMAE,
y 20.8 puntos en el grupo de la distrofia macular de Stargardt, a pesar de que
los datos no apoyan estos hallazgos.
Los
efectos adversos graves que ocurrieron fueron, cuatro ojos desarrollaron una
progresión de la catarata, un ojo desarrolló endoftalmitis, y un ojo desarrolló
inflamación vítrea severa. Aunque estas complicaciones no están directamente
relacionadas con las CME, la metodología para la colocación de las células era
responsable de las complicaciones. Ni las medidas del resultado, ni los efectos
adversos estaban relacionados con la cantidad de células trasplantadas, lo que
indica que se necesita más investigación para determinar el número óptimo de
células para el trasplante.
Los
resultados deben ser interpretados con un cauto optimismo. La idea del
trasplante de células retinianas no es nuevo, pero el método de trasplante de
las células en el borde de la zona atrófica para mejorar el suministro de
sangre al tejido trasplantado es una nueva estrategia.
Aunque
ninguno de los principales problemas de seguridad previstos, incluyendo la
formación de teratomas, el rechazo inmunológico, y la diferenciación
controlada, ocurrió en el estudio; seis de los 18 participantes (33%)
experimentaron otros efectos adversos importantes. El tamaño de la muestra era
tan pequeño que no hay análisis estadísticos posibles, poniendo en duda la
validez de los datos.
Los
resultados también deben ser interpretados con cautela debido a que la empresa
que financió el estudio, Advanced Cell Technology, participó en todos los
aspectos del estudio, creando la posibilidad de sesgo.
A
pesar de las preocupaciones mencionadas anteriormente, este estudio proporciona
evidencia de que incluso en casos avanzados de distrofia macular de Stargardt y
DMAE, las CME pueden sobrevivir e incluso restaurar un cierto nivel de agudeza
visual. Esto es obviamente un estudio muy temprano en el desarrollo de las CME,
y desde luego esperamos más y mejores resultados con las células Ips.

.jpg)

Comentarios
Publicar un comentario